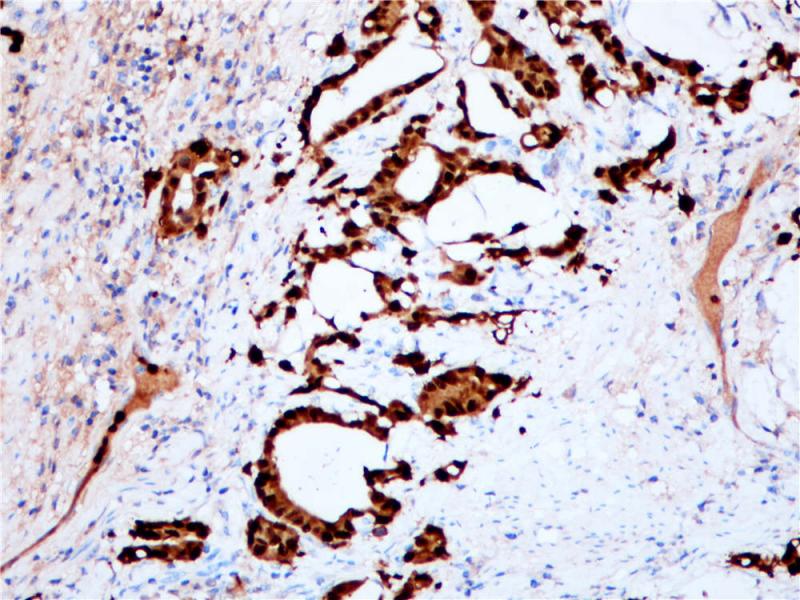
胃腺癌S100P(BP6018)染色

产品中心
胃腺癌S100P(BP6018)染色

胎盘S100P(BP6018)染色
S100P 重组兔单克隆抗体
S100P是一种由95个氨基酸组成的蛋白质,是S100家族的成员。S100P通过与Ca2+、晚期糖基化终产物受体、细胞骨架埃兹蛋白(ezrin)、钙周期结合蛋白(CacyBP/SIP)和组织蛋白酶D结合,调控肿瘤的生长、转移与侵袭。S100P在人胎盘、胃肠道、食管黏膜中是高表达,但在肝和胰腺中是阴性表达。S100P在乳腺癌、结肠癌、前列腺癌、胰腺癌和肺癌等几种癌症中呈现过表达。S100P与致癌有关。在不同的肿瘤中,S100P能作为一个潜在的诊断指标、预后和预测指标及治疗靶点。
Specifications
- 目录号
- BX50013
- 克隆号
- BP6018
- 阳性对照
- 胎盘
- 亚细胞定位
- 细胞质/细胞核
- 组织类型
- FFPE
- 修复方式
- HIER
- 稀释比
- 1:100-1:200
- 规格
- 100μl/vial, 1ml/vial
- 用途
- RUO
Reference
1.Jiang H et.al. J Cancer Res Clin Oncol. 2012 Jan;138(1):1-9.
2.Seppo Parkkila et.al. BMC Clin Pathol. 2008; 8: 2.


